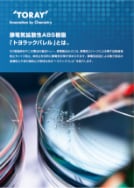

- HOME
- 資料ダウンロード
資料ダウンロード
「防水×振動レス×短タクトタイム」で注目!!レーザー溶着工法に適したPBT、PPS樹脂とは?
昨今の高機能化するデバイス部品の製造では、熱可塑性樹脂を高品質かつ高効率で接合する工程が求められます。内蔵される精密素子への影響がなく、かつタクトタイムを短縮するレーザー溶着工法において、より高品位かつ高効率となるPBT、PPS材料を紹介します。
高性能樹脂のレーザー溶着を実現レーザー溶着向けPBT、PPSの具体的使用方法とその特性
熱可塑性樹脂のレーザー溶着は、部品製造の生産性と質を高める工法として期待されます。レーザー溶着にPBTやPPSを用いる場合の具体的な方法や、それによって得られる部品の特性を解説します。
電子デバイス部品の信頼性確保に大きく貢献!PPS樹脂と封止材の結合力を飛躍的に向上
電子デバイス部品には、半導体材料の封止材としてエポキシ樹脂やシリコーン樹脂が使われます。外装材となる高機能性の熱可塑性樹脂と封止用の樹脂を十分に接着させることが、部品の信頼性を高める上で重要です。
静電気拡散性ABS樹脂「トヨラックパレル™」とは。
5G関連部材や二次電池の搬送トレー、家電製品などには、静電気スパークによる電子回路破壊防止やノイズ防止、埃防止を目的に静電気対策が求められます。静電気起因による電子部品の破壊防止や埃付着防止が期待出来るトヨラックパレル™を紹介します。
金属同等の熱膨張を実現!環境温度変化による寸法変化を極限に抑えた
超寸法安定PPS樹脂
軽量化や後加工レスを目的とした金属代替では、熱膨張の違いにより樹脂化困難な場合があります。東レは処方設計技術により、アルミや銅と同等の熱膨張を持つ、新規PPS樹脂を提案します。
PBT樹脂の弱点を克服!進化した東レの「耐加水分解技術」
ADAS部品などに使用されるPBT樹脂は、高温高湿度環境下に長期間晒されると加水分解により劣化し、強度低下を招きます。東レは新たに独自の樹脂改質技術を発明し、PBT樹脂の優れた特性(成形加工性、寸法精度、電気特性)を保持したまま、耐加水分解性を改良することに成功しました。
もう冷熱割れには困らない!PBT樹脂の「耐冷熱処方」と東レCAE解析活用事例
弊社はこれまで耐冷熱性を改良したPBT樹脂の開発と独自で保有するCAE解析ソフトを用いた事前検証結果をお客様に提供することで、金属樹脂複合部品における課題解決に貢献してきました。冷熱サイクルに適したグレードとCAE解析活用事例について紹介します。
東レPBT樹脂“トレコン™”深化した高耐久車載ソリューションをご提案!撥水技術と耐加水分解技術により「耐アルカリ性」を飛躍的に向上
クルマの進化を支えている各種ADAS製品は、周辺監視という部品機能から、過酷な環境で使用されることが多くなっています。PBT樹脂の弱点であるアルカリ耐性を従来比大幅に改良した、新規高耐久アルカリPBT樹脂をご紹介いたします。
電装部品の小型化・省スペース化を可能にPPS樹脂の耐トラッキング性“CTIランク0”を達成
クルマの電動化を中心に増加する電装部品の小型化、省スペース化の鍵となるのが絶縁材料の耐トラッキング特性です。車載電装部品等に幅広く採用されてきたPPS樹脂において、これまで不可能といわれていたCTIランク0(600V)を達成、その革新的な新材料について紹介いたします。
放熱性・電磁波シールド性・気密性と軽量化を両立新たな製品作りに貢献する金属樹脂接合技術のご提案
金属と樹脂を一体成形することで、放熱性、電磁波シールド性等の金属が持つ特性と、軽量化、易加工性等の樹脂の特性を併せ持つ製品設計が可能になりますが、気密性確保が重要な課題です。今回は、この課題を解決する金属樹脂接合技術の概要、適用事例、今後期待される用途についてご紹介します。
グローワイヤー規格対応 高耐燃焼性ナイロン樹脂アミラン™ CM6004-VG
グローワイヤー試験において高い温度に対応している材料は、最終製品の認証において、製品の適用領域が拡がる、製品側での試験が免除されるなどといったメリットがあります。本資料では、優れたグローワイヤー特性に加え、難燃性、耐トラッキング性、靭性を兼ね備えたナイロン樹脂を提案します。
金属代替による配管一体化などを実現可能に極限に挑戦!柔らかさ世界最高レベルの超柔軟PPS
東レが新たに開発したPPS樹脂で世界最高レベルの柔らかさを持つ“超柔軟PPS”は、あらゆる成形工法に対応が可能であり、配管の金属代替や組み付け工程の簡略化、部品点数削減、フッ素樹脂や熱硬化性ゴム等の素材代替など、お客様に新たな価値をご提供できる様々な可能性を秘めております。
金属レスで電子部品の電磁波対策に貢献!! 炭素繊維強化熱可塑性樹脂 トレカ™の電磁波シールド性
5G、 IoT、ADAS等の普及による電子機器の増加に伴い電磁波対策が課題となってきています。本資料では、そのような課題を解決する電磁波シールド性にすぐれた炭素繊維強化熱可塑性樹脂トレカ™の特性と適用検討事例についてご紹介します。
USCAR 規格クラスIV以上に対応する東レの高耐久PBT樹脂 トレコン™ “5008”シリーズ
自動車電装部品の多くに、PBT 樹脂が適用されていますが、高温高湿度環境では樹脂劣化による強度低下を招くため、耐久性向上が求められています。東レは、従来の耐加水分解技術を飛躍的に向上させて、 USCAR 規格の T4(150°C)以上に対応した“5008”シリーズを開発しました。
ガルバノスキャニングレーザー溶着の特長を最大限に引き出す生産性向上に貢献する、PBT樹脂 トレコン™ 1251G-30 HL
近年、車載部品の接合工法として、高い溶着品質をもつガルバノスキャニングタイプのレーザー溶着の採用が拡大しています。 東レは、PBT 樹脂の特性はそのままに、ガルバノスキャニングレーザー溶着に最適な、レーザー高透過PBT 樹脂 トレコン™ 1251G-30 HL を開発しました。
性能確認用試作部品や最終部品の短納期・低コスト化が可能に!世界初!3Dプリンタ対応高機能ポリマー微粒子
"トレミル®PPS"と用途展開
3Dプリンタ(粉末床溶融結合方式)用に開発・最適化した高機能ポリマー微粒子“トレミル®PPS”をご紹介致します。主に、少量多品種の機能性確認用試作や最終部品に採用頂いております。
性能確認用試作部品や最終部品の短納期・低コスト化が可能に! モーター、水周り部品向け3DプリンタPPS造形物
PPS の耐熱性、耐薬品性、電気特性、低吸水性などの特徴を活かしたモーター、水周り向け機能性試作部品をご紹介致します。3Dプリンタを活 用することにより既存工法と比較し、短納期、低コストなどのメリットがあります。
リサイクル可能なCF強化グレードにより軽量化、
帯電防止、シールド性と経済性を両立!
3Dプリンタ対応CF強化高機能ポリマー微粒子
"トレミル®PPS"とその用途展開
3Dプリンタ用PPSにCF(カーボンファイバー)を添加した強化グレードをご紹介致します。
機械特性が求められる自動車、ロボット、航空宇宙用途へ適用することが可能です。
3Dプリンタと切削加工の組み合わせによる面粗度(Ra1.6-3.2μm)、寸法精度(±0.05mm)実現機能性試作部品、最終製品でのPPS/3D造形物の採用事例拡大
切削での追加工や設計提案により、従来からの3D造形物の課題であった面粗度や寸法精度を改善し、機能性試作部品や最終製品への展開を推進しております。
高剛性・高耐熱・高品位の3D造形物で後加工レスを実現!
3Dプリンタ対応高機能真球ポリマー微粒子
"トレパール®PA6"とそのアプリケーション
3Dプリンタ(粉末床溶融結合方式)用に開発・最適化した高機能真球ポリマー微粒子“トレパール®PA6”をご紹介致します。
3D造形物の高い表面平滑性や気密性により、後加工の削減に貢献します。主に少量多品種の機能性確認用試作や最終部品に採用頂いております。
東レの環境配慮型樹脂のご提案
東レは、持続可能な社会の実現に向けて、リサイクル原料を活用した樹脂製品の開発に取り組んでいます。生産工程で発生する端材(PIR材)や使用済み製品から回収した材料(PCR材)を原資とし、マテリアルリサイクルおよびケミカルリサイクルの手法を用いて、独自の処方設計と品質保証を行ったリサイクル樹脂を展開しています。
また、更なる環境負荷低減を目指し、バイオマスナフサ由来の原料を使用したABS樹脂およびPPS樹脂のご提案も進めています。